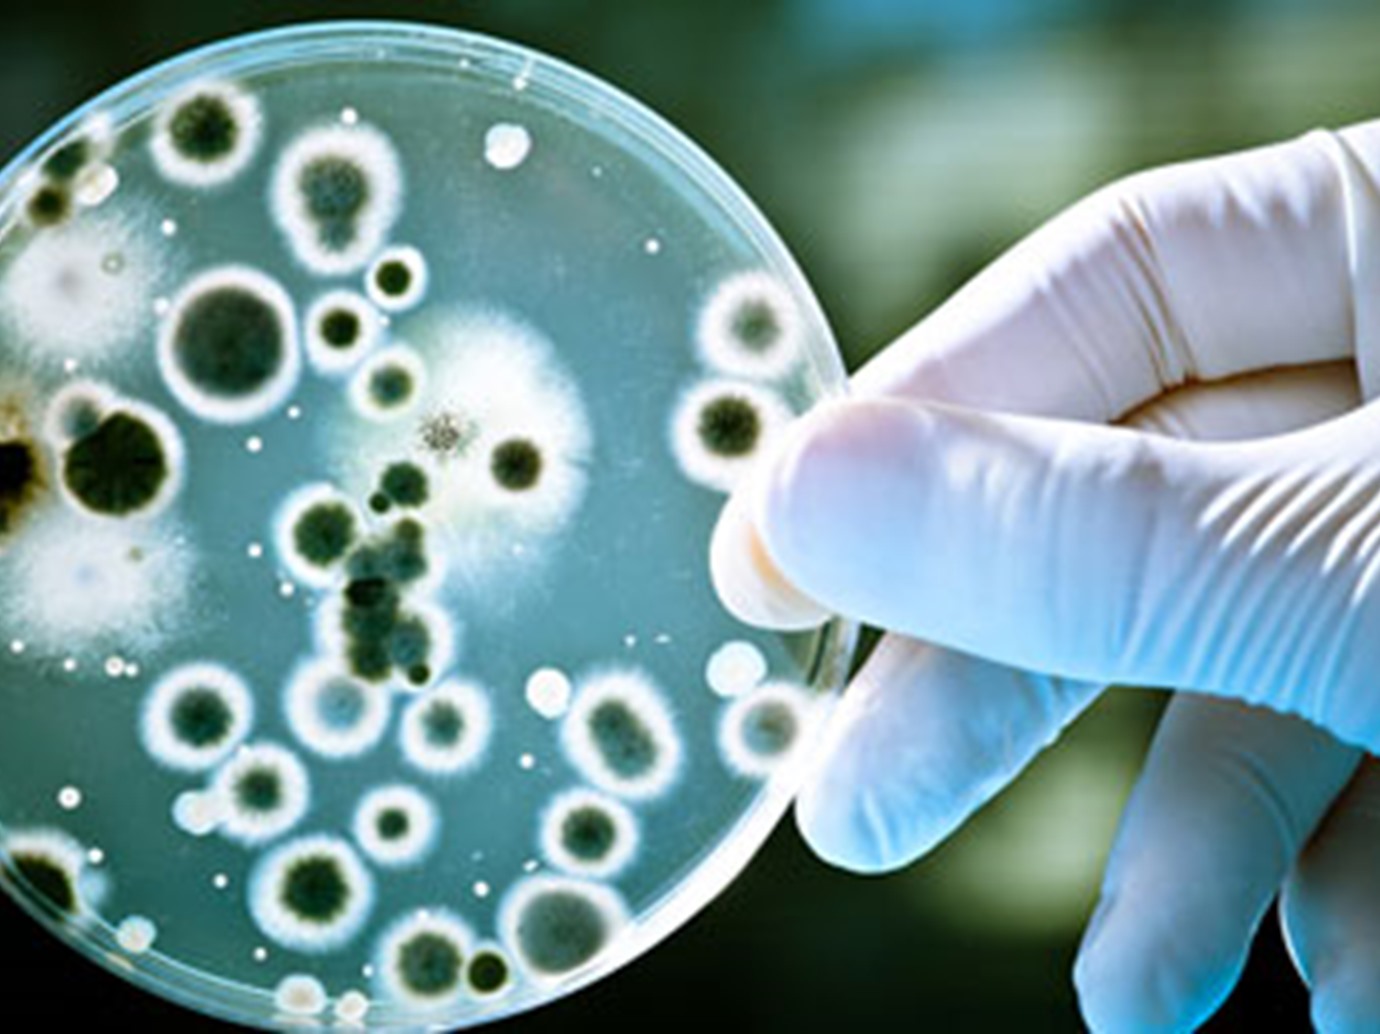
alarab

7 أنواع من البكتيريا تهدد حياة الإنسان
منوعات
06 مايو 2016 , 11:36ص
متابعات
البكتيريا هي عبارة كائنات صغيرة تتواجد في الخضار، الماء والهواء وتدخل الى جسم الإنسان في كثير من الأحيان دون علمه، وبعض أنواع البكتيريا هو بغاية الخطورة ويشكل خطراً على حياة الإنسان وقد يؤدي الى الوفاة.
ويوجد من البكتيريا عدة أنواع وبعضها مفيد لصحة الإنسان وبعضها الآخر يهدد حياته ويسبب العديد من الأمراض. أما أبرز أخطر أنواع البكتيريا التي تهدد حياة الإنسان، هي كالآتي:
1- ايشيريشيا كولاي: تعتبر هذه البكتيريا خطيرة وهي تعيش داخل أمعاء الإنسان السليم. بعض أنواع " ايشيريشيا كولاي" يشكل خطراً كبيراً على الأطفال والأشخاص الذين يعانون من مشاكل في الجهاز المناعي وقد تؤدي الى حدوث نزيف في الأمعاء.
2- كلوستريديوم بوتولينوم: تصنف هذه البكتيريا بالسامة ويهاجم البوتيولينم الجهاز العصبي للشخص المصاب مما يؤدي الى صعوبات في التنفس، والبلع، والرؤية. كما تؤدي هذه البكتيريا الى فقدان الوزن وإلى حدوث شلل في عضلات التنفس مما قد يؤدي الى وفاة الشخص.
3- السالمونيلا : تعتبر السالمونيلا بكتيريا قاتلة، تنتقل عبر الإحتكاك ببراز أو بول شخص مصاب أو عبر تناول لحوم ودجاج غير مطهي جيداً.
4- فيبريو كوليرا : ان هذه البكتريا مسببة لمرض الكوليرا وهي تنتقل عبر شرب ماء ملوث ببراز الإنسان. ومن أعراض الإصابة بالكوليرا الإصابة بالإسهال المزمن، والجفاف.
5- الكزاز: يصاب الإنسان بكتيريا الكزاز عندما يتعرض لإصابة ما أو جرح. إن الأشخاص الذين حصلوا على طعم الكزاز لا تشكل البكتريا خطراً عليهم، ولكن الذين لم يحصلوا على الطعم عليهم فورا الحصول على مصل ضد الكزاز في حال تعرضوا لجرح أو إصابة. تؤدي الإصابة بهذه البكتيريا إلى أعراض شديدة كالتشنج في عضلات الفك وإنقباض عضلات في مختلف أنحاء الجسم؛ وفي حال حدوث ذلك يجب التوجه فوراً الى المستشفى للمعالجة.
6- الرشاشيات: تنتشر هذه البكتيريا في مكيفات الهواء، وتؤثر الإصابة بها على دم الإنسان والجهاز التنفسي وقد تؤدي الى الوفاة في حال عدم المعالجة. ان مرضى السرطان والأشخاص المصابين بأمراض نقص المناعة معرضين أكثر من غيرهم للإصابة بهذه البكتيريا.
7- البكتريا العنقودية: تعتبر من أخطر أنواع البكتريا التي تفتك بالإنسان ويمكنها أن تقضي على الإنسان إذا كان جهازه المناعي ضعيف لا سيما أن هذه البكتيريا متشعبة وبعض أنواعها يقاوم المضادات الحيوية. ويرجح أن الأسباب المؤدية الى ظهور هذه البكتيريا الإفراط في استخدام المضادات الحيوية لا سيما الفانكومايسين. تؤدي هذه البكتيريا الى تآكل اللحوم وقد يضطر الفريق الطبي الى بتر عضو المريض المصاب للحد من إنتشار المرض.
ح.أ